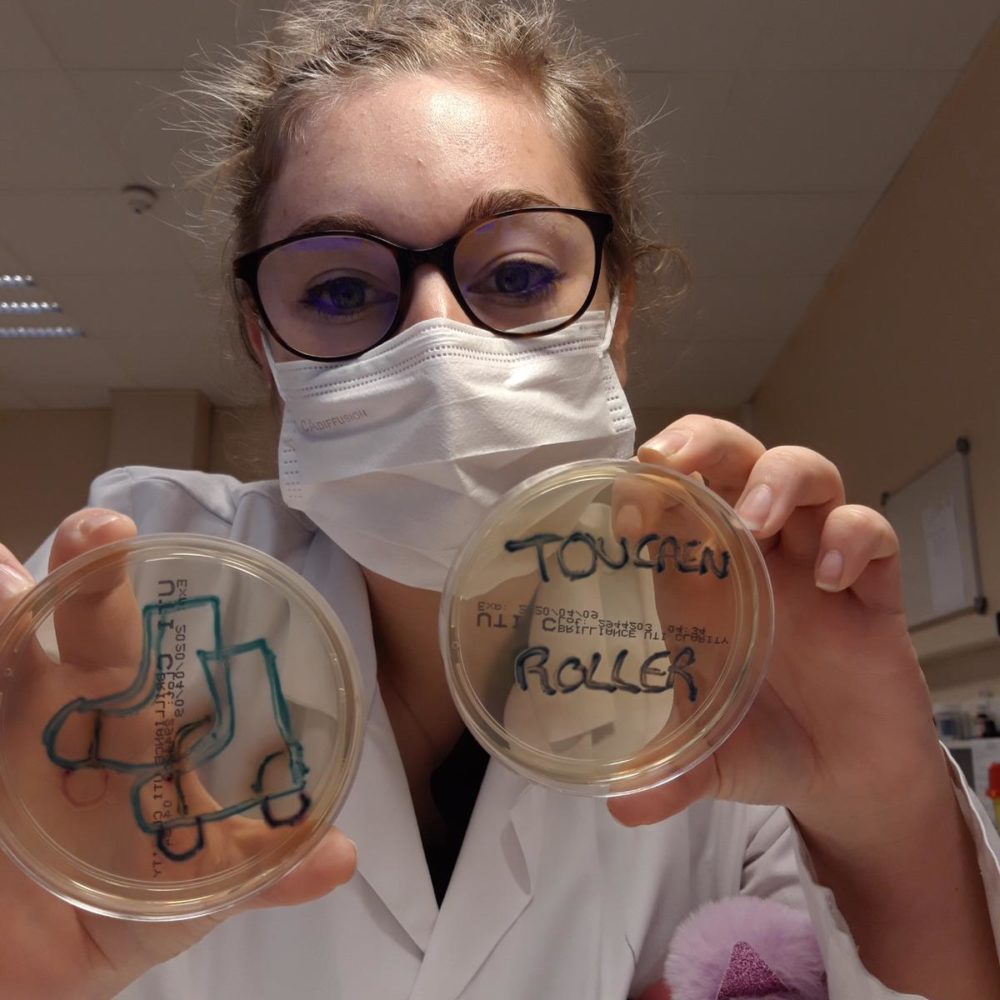

#JeResteChezMoiEnRollers
En cette période un peu particulière, nous nous imposons de garder le contact ! Et oui, parce qu’au delà de la découverte, de la pratique ou encore du perfectionnement en Rollers, le Club reste un lieu de rencontres, d’échanges et de partages.
Alors, on ne va pas se laisser abattre et on va continuer à se donner des nouvelles jusqu’à ce qu’on se retrouve tous, pour fêter le retour à la normale. Et pour se faire, on va suivre les consignes et rester chez nous évidemment (sauf pour ceux qui ont l’obligation de rester « au contact ») mais on va quand même partager des scènes de nos vies quotidiennes. On a commencé à le faire sur la Page Facebook du TouCaen Roller mais on diffusera également vos plus beaux clichés sur le site du Club, c’est à dire ici !
On attend vos photos ou vidéos via contact@toucaenroller.fr, et du coup, pour vous donner un peu de baume au cœur, voici les premiers artistes à ouvrir le bal. Merci d’avance de nous donner de vos nouvelles, et n’oubliez pas, prenez soins de vous, et restez chez vous… en rollers #JeResteChezMoiEnRollers